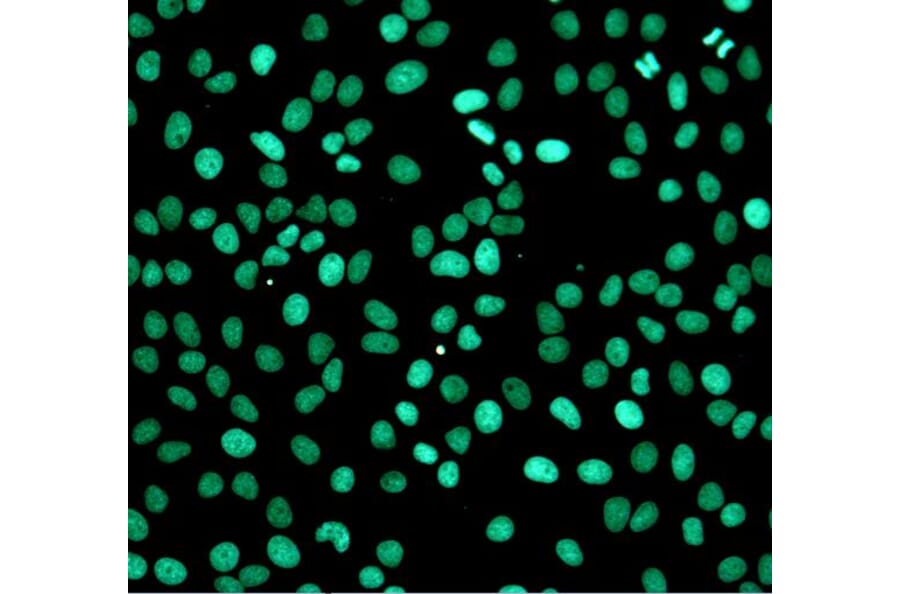
Apoptosis

Determining cellular state and the activity of metabolic pathways in cells are essential for many aspects of biomedical research and drug discovery. Cell-based assays are used to precisely measure cellular responses to a variety of internal and environmental stimuli such as development, ageing, and inflammation, in addition to being general indicators of cell health.
Cell-based assays provide direct readouts of cellular function, resulting in more physiologically relevant data that reflects complex biological pathways, including:We offer over 150 cellular and biochemical assays for detecting and quantifying cellular processes in a wide variety of model organisms and sample types, including monolayer cell cultures, primary cells, stem cells, and organoids.
We also have a wide range assays and kits for measuring, isolating or visualizing proteins, DNA and RNA in cell and tissue samples.
Also known as programmed cell death, apoptosis occurs to remove cells that are no longer needed or are damaged beyond repair. Hallmarks of apoptosis include DNA fragmentation, cell membrane reorganization, blebbing, and shrinkage. We offer Annexin V Staining kits, TUNEL and Comet assays, and Caspase Kits to assess apoptosis.

Cell viability and proliferation assays can be indicators of cell health, or of cytotoxicity in unfavorable conditions. Our cellular health kits include measurements of lactate dehydrogenase, cell counting kits, and live/dead staining.

Cells move toward or away from specific external stimuli during development, wound healing, immune responses and tissue invasion. In vitro evaluations of cell migration are typically performed using long-lasting, non-toxic fluorescence to track cells, or semi-permeable membranes through which cells can detect chemoattractant gradients.